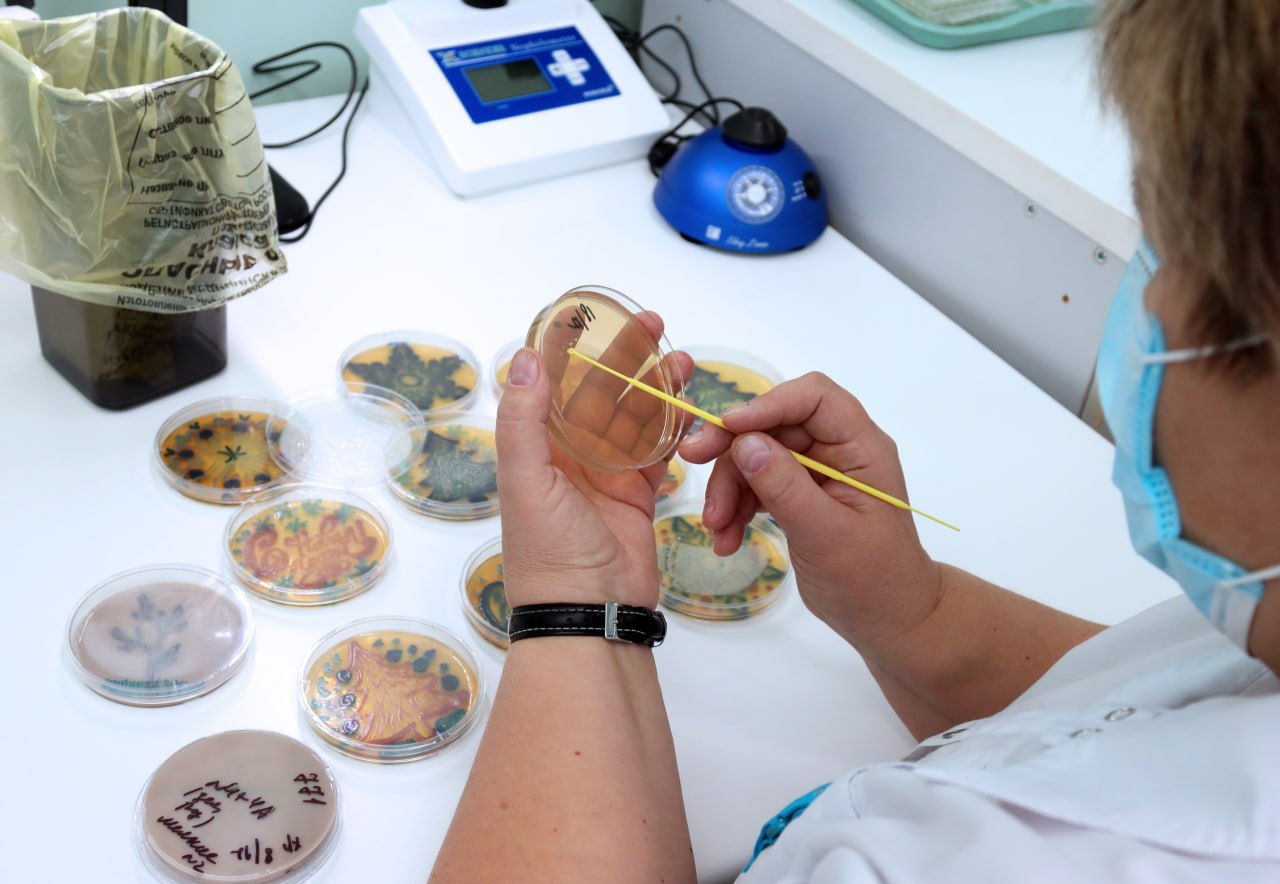
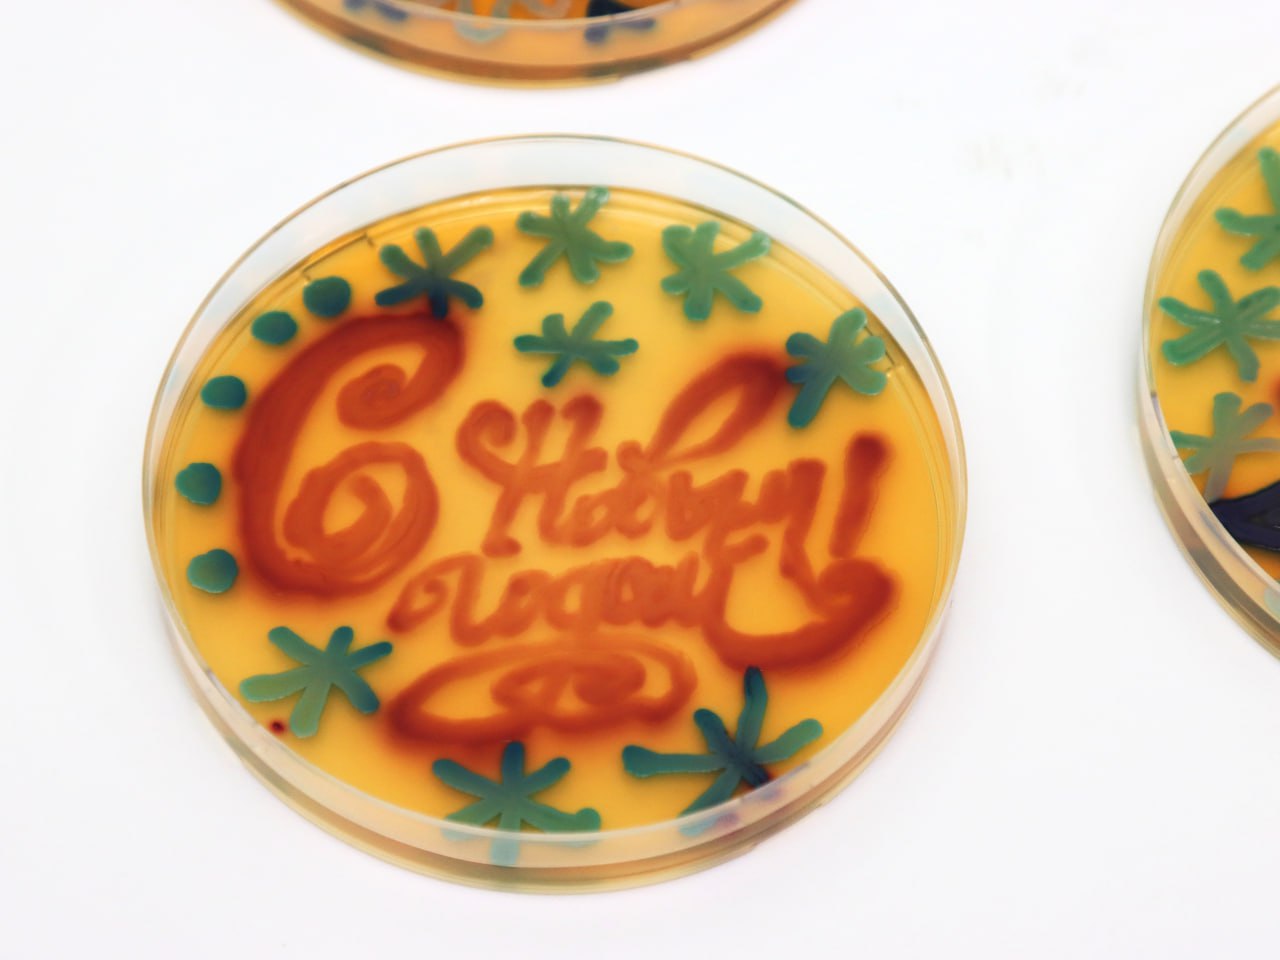

Учёные Центра Илизарова нарисовали снежные узоры бактериями.
Накануне новогодних праздников сотрудники лаборатории микробиологии Центра Илизарова продемонстрировали удивительные рисунки, созданные с помощью бактерий, а не красок.
На питательных средах в чашках Петри ученые вырастили новогодние елки, снежинки и праздничные поздравления. Для создания таких необычных зимних пейзажей использовались различные виды микроорганизмов.
Зеленый цвет был достигнут благодаря клебсиеллам, синий – энтерококкам, белый – стафилококкам, а красный – кишечной палочке.